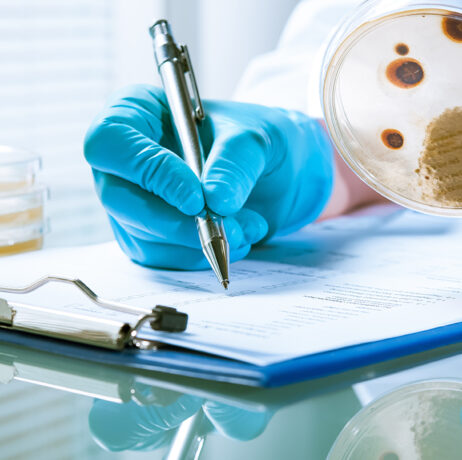

DISTRIWEL - Culture media dispensing
MEDIA PREPARATION : THE PLATE POURING METHOD
Nowadays, microbiology labs are using several methods for inoculation on a Petri dish. We have the « Spread Plate Method » and the « Plate Pouring Method ». The « Spread Plate Method » consists in dropping your sample on culture media. With this method you can easily isolate the colonies and simplify their retrieval, for...
Read the Article